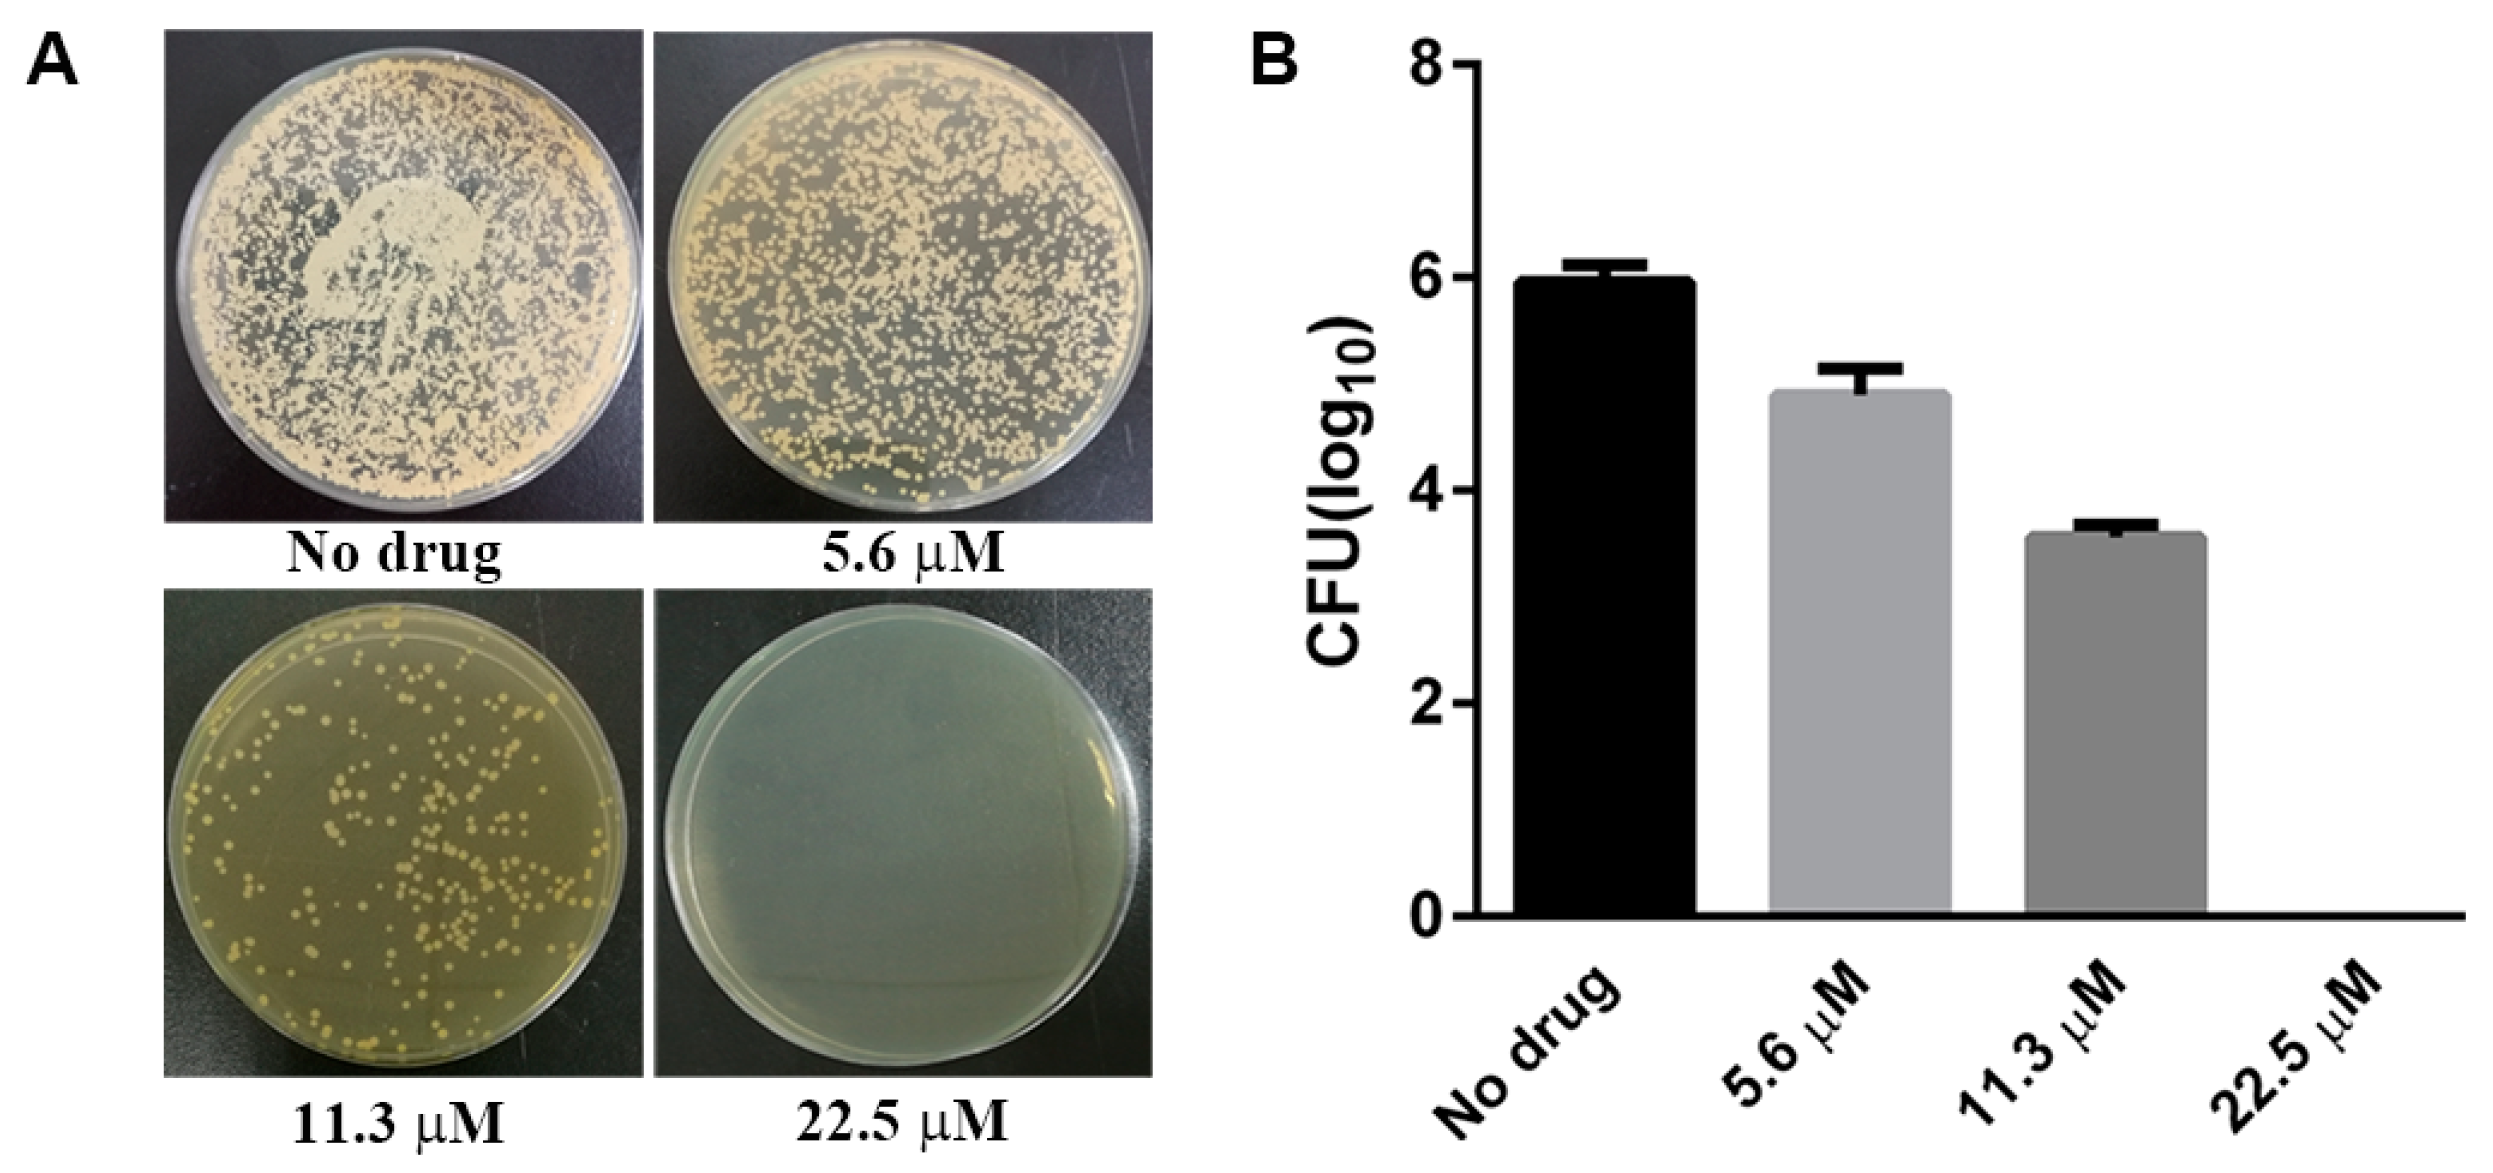
Molecules 22 00637 g002

Abstract
Octahedral transition metal complexes have been shown to have tremendous applications in chemical biology and medicinal chemistry. Meanwhile, structural transition metals can be replaced by inert octahedral silicon in a proof-of-principle study. We here introduce the first example of octahedral silicon complexes, which can very well serve as an efficient antimicrobial agent. The typical silicon arenediolate complex 1 {[(phen)2Si(OO)](PF6)2, with phen = 1,10-phenanthroline, OO = 9,10-phenanthrenediolate} exhibited significant inhibition towards the growth of Cryptococcus neoformans with MIC and MFC values of 4.5 and 11.3 μM, respectively. Moreover, it was fungicidal against both proliferative and quiescent Cryptococcus cells. This work may set the stage for the development of novel antifungal drugs based upon hexacoodinate silicon scaffolds.
1. Introduction
Cryptococcosis is an invasive mycosis associated with significant morbidity and mortality [1]. Cryptococcal meningitis, caused by Cryptococcus neoformans, leads to approximately 600,000 deaths from 1,000,000 infections annually [2], which is even exacerbated by the emergence of drug resistance [3,4,5,6]. Currently, an acute cryptococcal infection is treated with amphotericin B or azole in combination with 5-flucytosine [7]. However, due to the renal toxicity and lack of oral formulations of amphotericin B, hematological toxicity of 5-flucytosine [8], and the surge of drug resistance, there is an urgent need for the development of new antimicrobials. Exploring novel antifungal agents with new mechanism or chemical structure is intensely desired [9,10].
Several years ago, one of us reported the first examples of designed biologically active complexes based on octahedral silicon and found that silicon complexes can be viewed as template-substituent of ruthenium complexes [11,12,13]. As a structural octahedral center, the metalloid silicon owns distinct advantages over transition metals, such as a lack of toxicity concerns and high stability in configuration [14,15]. Similarly, as the octahedral polypyridyl ruthenium complexes, hexacoordinate silicon arenediloate complexes could intercalate and remarkably stabilize DNA duplex, which means enormous biological application potentiality [16,17,18,19,20].
2. Results and Discussion
2.1. Antimicrobial Activity
Firstly, we carefully studied antimicrobial activities of the typical octahedral silicon complex 1, and two ruthenium complexes—2 {[(phen)3Ru](PF6)2, with phen = 1,10-phenanthroline} and 3 {[(bpy)3Ru](PF6)2, with bpy = 2,2′-bipyridine}—with an analogous structure as control compounds (Figure 1). The antibacterial and antifungal activities of the complexes 1–3 were firstly investigated with Kirby–Bauer disc diffusion assays [21]. In this assay, five different bacterial strains (Staphylococcus aureus MRSA and MSSA, Escherichia coli, Pseudomona saeruginosa PAO1, and Acetobacter baumannii) and two fungal strains (Candida albicans and Cryptococcus neoformans) were plated on an agar dish, and disks soaked with solution of the complexes 1–3 (25 μg) or with ampicillin (25 μg) as the positive control for bacteria or fluconazole (25 μg) as the positive control for fungi. After 24 h for bacterial strains, or 48 h for fungal strains, the growth inhibition zones of the test strains were determined. As shown in Figure 1, the ruthenium complexes 2 and 3 did not show any obvious antimicrobial activity. In contrast, the silicon complex 1 displayed potent anti-bacterial activity towards S. aureus, including the MRSA, whereas it was inactive to Gram-negative bacteria (E. coli, P. aeruginosa, and A. baumannii). More interestingly, Complex 1 exhibited selective anti-fungal activity towards C. neoformans, one major opportunistic fungal pathogen, which could cause systemic infections that are commonly involved in the central nervous system (CNS).
Figure 1.
Anti-bacterial and anti-fungal activity of Complex 1 as determined by the disk diffusion assay. (A) Chemical structures of Complexes 1, 2, and 3. (B) Strains including C. neoformans H99, C. albicans ATCC90028, S. aureus ATCC 33591(MRSA), ATCC 25923(MSSA), E. coli ATCC25922, P. aeruginosa PAO1, and A. baumannii, a clinical strain resistant towards β-lactam antibiotics. The corresponding substances in the schematic figure: Complex 1 (1), Complex 2 (2), Complex 3 (3), DMSO (4), or water (6) was used as negative control; ampicillin (5) was used as a positive control for antibacterial agents and fluconazole (5) as a positive control for antifungal agents, respectively.
2.2. Determination of MIC Values
Based on the selective anti-fungal activity that Complex 1 exhibited, we further determined the minimum inhibitory concentration (MIC) value of Complex 1 against C. neoformans. Accordingly, serial solutions of Complex 1 prepared in DMSO with concentrations ranging from 0.56 to 71.68 μM were added to mid-log phase of C. neoformans and incubated 2 days to observe the cell growth. The MIC was determined as the lowest concentration of Complex 1 inhibiting visible fungal growth. Meanwhile, we also set the ruthenium complexes 2 and 3 and typical positive drugs (fluconazole, amphotericin B, and 5-flucytosine) as the control group and determined the MIC values as well. As displayed in Table 1, it is not surprising that amphotericin B inhibited the best antifungal activity against the growth of C. neoformans with an MIC value of 0.3 μM. However, the results showed that the MIC value of Complex 1 was 4.5 μM, which exhibited better antifungal activity than fluconazole (6.5 μM) and was comparable to 5-flucytosine (3.9 μM). In contrast, the ruthenium complexes 2 and 3 showed only very limited activity against C. neoformans, with MIC values of 34.3 μM and 74.4 μM, respectively. We are convinced that the silicon complex could exhibit better antifungal activity with proper modification in the future.
Table 1.
In vitro anti-fungal activity towards C. neoformans of Complexes 1–3 and typical positive control drugs (MIC, μM).
2.3. Determination of MFC Value of Complex 1
Considering the selective anti-fungal activity towards C. neoformans was our capital concern, we only focused on the cryptococcal relevant work of Complex 1 in the following study. We next determined the minimum fungicidal concentration (MFC) of Complex 1 following the agar dilution method [22]. Briefly, C. neoformans inoculums treated with different concentrations of Complex 1 for 24 h were taken and plated on drug-free yeast extract–peptone–dextrose (YPD) agar and incubated for another 2 days to measure colony-forming units (CFUs). The MFC was considered the lowest concentration of Complex 1 that allowed less than 0.1% of the original inoculum treated with Complex 1 to grow on the surface of the agar. As displayed in Figure 2, the results showed that the number of CFU were consistent with decreasing amounts of drug and the MFC of C. neoformans grown with Complex 1 was 11.3 μM.
Figure 2.
Inhibition of the growth of C. neoformans by Complex 1 as determined by the broth dilution method. (A) Qualitative analysis of colonies at the different concentrations of Complex 1; (B) Quantitative analysis of colony-forming units (CFUs) at the different concentrations of Complex 1. Results are representative of three independent experiments. CFUs were determined at 48 h after incubation and are reported as an average ± S.D.
2.4. A Comparative Time-Course Assay of Cell Viability
It is commonly known that drugs that can kill fungal pathogens lead to a quick reduction of fungal burden and the restriction of the prevalence of drug-resistant strains [23,24,25]. To investigate whether Complex 1 is fungistatic or fungicidal, a comparative time-course assay of cell viability was performed. We cultured C. neoformans H99 cells in an RPMI1640 medium or in a PBS buffer to represent rapidly proliferative or quiescent cells respectively. These cells were then treated with no drug or with Complex 1. At different time points, aliquots of cell suspensions were spread onto the drug-free YPD medium to determine the number of viable cells by measuring the CFUs. Figure 3 reveals that the number of viable cryptococcal cells began to decrease at 12 h in the presence of Complex 1 in RPMI, which was contrary to the no-drug control, and there were no viable cells left after 24 h of incubation. Similarly, H99 cells in PBS were cleared by Complex 1 after 24 h of incubation. These results demonstrated that Complex 1 was able to kill fungal cells independently regardless of what growth stage the cells were in.
Figure 3.
Complex 1 is fungicidal against both proliferative and quiescent Cryptococcus cells. (A) H99 cells were inoculated into RPMI1640 and (B) into PBS, and cultured without any drug (control) or in the presence of Complex 1 (17.92 μM). At the indicated time points, aliquots of cell suspensions were transferred and plated on the drug-free yeast extract–peptone–dextrose (YPD) medium to determine CFUs after 48 more hours of incubation. Fungal cells proliferated rapidly in the absence of any drugs, but they were gradually killed with Complex 1 treatment.
2.5. Antifungal Mechanism
Finally, we preliminarily investigated the antifungal mechanism of Complex 1. Since Complex 1 did exhibit a strong stabilization of DNA duplex in vitro [11], we speculated that genomic DNA of C. neoformans might also be a potential target of Complex 1. Therefore, we tested the effects of Complex 1 on the growth of C. neofromans in the absence and presence of exogenous salmon sperm DNA (ssDNA). As shown in Figure 4, when the concentration of Complex 1 ranged from 0.28 to 8.96 μM, it did significantly affect the antimicrobial activity because of the existence of exogenous DNA. Apparently, exogenous DNA could weaken the efficacy of Complex 1 and rescue C. neoformans from growth inhibition to a certain extent. The result also showed that the dosage of Complex 1 with exogenous DNA had to be increased from 8.96 to 13.44 μM to achieve a 100% killing rate, compared to the control group, suggesting the antifungal process may be relevant with DNA binding.
Figure 4.
Killing rate of Complex 1 in the absence and presence of exogenous DNA. ssDNA with a concentration of 100 μg/mL was incubated with different concentrations of Complex 1 for 30 min and added to C. neoformans culture for treatment for about 24 h. The number of viable cells was determined by plating the suspension on drug-free solid media and then measuring CFUs.
3. Materials and Methods
All reactions were carried out under an argon atmosphere. Chloroform was distilled under nitrogen from calcium hydride. 1,10-Phenanthroline was sublimated before use. Ampicillin and fluconazole were brought from Meilun Biotech Co. (Dalian, China), morpholinepropanesulfonic acid, and Salmon Sperm DNA were obtained from Sigma-Aldrich (St. Louis, MO, USA). Their stock solutions were freshly prepared, filter-sterilized, and used at indicated concentrations. SiI4 was purchased from Alfa, and the other reagents were purchased from Sigma, Acros, or Strem and used without further purification. Column chromatography was performed with silica gel (230–400 mesh). 1H- and 13C-NMR spectra were recorded on a Bruker Advance (400 MHz, Bruker Corporatio, Billerica, MA, USA) at ambient temperature.
In total, the following bacterial and fungal strains were used for this study: Cryptococcus neoformans H99, Candida albicans ATCC90028, Staphylococcus aureus ATCC 33591(MRSA), ATCC 25923(MSSA), Escherichia coli ATCC25922, Pseudomonas aeruginosa PAO1, and clinical isolated Acetobacter baumannii. S. aureus, E. coli, and P. aeruginosa were grown in TSB medium; C. neoformans and C. albicans were grown in YPD medium. These strains were stored as glycerin stock in −80 °C.
3.1. Syntheses
The silicon complex 1 was synthesized by modified literature procedures (Figure 5) [11]. Accordingly, a suspension of silicon(IV) iodide (2.0 g, 3.74 mmol) and 1,10-phenanthroline (1.5 g, 8.37 mmol) in freshly distilled CHCl3 (50 mL) was purged with Argon for 15min and was heated to 55 °C for 72 h under argon. The resulting brownish red suspension was cooled to room temperature and filtered to remove the solvent. The solid was washed with dry CHCl3 (2 × 25 mL), MeOH (25 mL), and Et2O (25 mL) successively and was subsequently dried in vacuum to afford the deep-brownish solid 1A (2.6 g, 77%), which could be used directly for the next step without further purification. In addition, phenanthrene-9,10-diol (Compound 1B) was prepared exactly according to the published procedures [26].
Figure 5.
Synthetic route of Complex 1.
A suspension of 1A (200 mg, 0.22 mmol) and 4 equivalents of 1B (185 mg, 0.88 mmol) in freshly distilled CHCl3 (30 mL) was purged with argon for 15 min and then stirred at 55 °C for 3 h. The resulting dark-brown suspension was cooled to room temperature, and the solvent was removed in vacuo. The residue was dissolved in 5 mL of mixed solvent {CH3CN:H2O:KNO3(sat.) = 100:3:1} and subjected to silica gel chromatography with CH3CN first and afterward switched to CH3CN:H2O:KNO3(sat) = 200:3:1 and CH3CN:H2O:KNO3(sat) = 100:3:1. The product eluents were concentrated and redissolved in 10 mL of water, and the product was precipitated by the addition of excessive solid NH4PF6. The precipitate was centrifuged, washed twice with water (2 × 10 mL), and dried to afford the pure diolate complex 1 as a pale-brown solid (52 mg, 27%). The NMR data of Complex 1 were consistent withthe reported data [11].
The ruthenium complexes 2 and 3 [27] and phenanthrene-9,10-diol [28] (1B) were prepared according to the published procedures.
3.2. Disk Diffusion Susceptibility Test
The disk diffusion method was used to determine sensitivity of bacteria and fungi to Complexes 1–3 [21]. Bacteria and fungi direct colony suspensions were prepared in TSB and YPD from overnight culture, respectively. The turbidity of five different bacterial and two fungal suspensions were standardized to match 1.0 × 108 CFU/mL. A sterile swab dipped in fresh bacterial or fungal suspensions were inoculated to the entire surface of TSB or YPD agar and inoculum was distributed evenly. Five microliters of complexes 1–3 (25 μg), ampicillin (25 μg), and fluconazole (25 μg) were impregnated on sterile paper disks for 15 min. Subsequently, the paper disks were aseptically placed on and pressed down firmly to the inoculated plates. Plates were incubated for 24 h for bacteria and C. albicans, and 48 h for C. neoformans in a 37 °C incubator. After incubation, the inhibition zones were measured. The presence or absence of growth around the disks was a measure of the ability of complexes 1–3 to inhibit the growth of bacteria and fungi. All experiments were done in triplicate.
3.3. Determination of MIC and MFC Values
The MIC values were determined using the broth microdilution methods developed by the Clinical and Laboratory Standards Institute (CLSI) and published in document M27-A3 [22]. RPMI1640 with 0.165 M morpholinepropanesulfonic acid (MOPS) (pH 7.0) was used as the test medium.
The final concentrations of antifungal agents studied ranged from 0.14 to 71.68 μM for Complex 1. The cell suspensions were diluted with the test medium to obtain an inoculum size of 1 × 103 CFU/mL for C. neoformans H99. MICs were determined after incubation at 37 °C for 48 h. The MIC endpoints were defined as the lowest drug concentration that leads to a reduction in growth of 50% or more compared with the growth. The MFC was considered as the lowest concentration of Complex 1 that allowed less than 0.1% of the original inoculum.
3.4. Anti-Fungal Activity of Complex 1 on C. neoformans in the Presence of ssDNA
Salmon Sperm DNA (ssDNA) (Sigma-Aldrich) with a concentration of 100 μg/mL was incubated with different concentrations of Complex 1 for 30 min in a 37 °C incubator. Then, the mixture was added to the C. neoformans culture and incubated at 37 °C for 24 h in tubes with constant shaking. The number of viable cells was determined by plating the suspension on drug-free solid media and then measuring CFUs.
4. Conclusions
In conclusion, we here reported for the first time that the octahedral silicon complex 1 can very well serve as an efficient antimicrobial agent. The silicon complex not only significantly inhibited the growth of S. aureus but also displayed selective antifungal activity against C. neoformans. Although the exact antimicrobial mechanism of this silicon complex needs to be further investigated, we are convinced that this work will pave the way to the development of novel hexacoordinate silicon-based antifungal drugs. Work along these lines as well as the biological applications of other silicon complexes with analogous structures are in progress.
Acknowledgments
This work was financially supported by the following: the State Key Laboratory of Mycology, Institute of Microbiology, Chinese Academy of Sciences; the National Natural Science Foundation of China (Grant 21601146); the Fundamental Research Funds for the Central Universities (Grant XDJK2015C157).
Author Contributions
C. Fu performed the experiments and wrote the paper; B. Fu also performed partial experiments; X. Peng analyzed the data; G. Liao designed the study and wrote the paper. All authors have given approval to the final version of the manuscript.
Conflicts of Interest
The authors declare no competing financial interests.
Abbreviations
YPD: yeast extract–peptone–dextrose; CFU: colony-forming unit; PBS: phosphate-buffered saline; MOPS: morpholinepropanesulfonic acid; ssDNA: Salmon Sperm DNA.
References
- May, R.C.; Stone, N.R.; Wiesner, D.L.; Bicanic, T.; Nielsen, K. Cryptococcus: From environmental saprophyte to global pathogen. Nat. Rev. Microbiol. 2016, 14, 106–117. [Google Scholar] [CrossRef] [PubMed]
- Park, B.J.; Wannemuehler, K.A.; Marston, B.J.; Govender, N.; Pappas, P.G.; Chiller, T.M. Estimation of the current global burden of cryptococcal meningitis among persons living with hiv/aids. AIDS 2009, 23, 525–530. [Google Scholar] [CrossRef] [PubMed]
- Bicanic, T.; Harrison, T.; Niepieklo, A.; Dyakopu, N.; Meintjes, G. Symptomatic relapse of hiv-associated cryptococcal meningitis after initial fluconazole monotherapy: The role of fluconazole resistance and immune reconstitution. Clin. Infect. Dis. 2006, 43, 1069–1073. [Google Scholar] [CrossRef] [PubMed]
- Sionov, E.; Chang, Y.C.; Kwon-Chung, K.J. Azole heteroresistance in cryptococcus neoformans: Emergence of resistant clones with chromosomal disomy in the mouse brain during fluconazole treatment. Antimicrob. Agents Chemother. 2013, 57, 5127–5130. [Google Scholar] [CrossRef] [PubMed]
- Yamazumi, T.; Pfaller, M.A.; Messer, S.A.; Houston, A.K.; Boyken, L.; Hollis, R.J.; Furuta, I.; Jones, R.N. Characterization of heteroresistance to fluconazole among clinical isolates of cryptococcus neoformans. J. Clin. Microbiol. 2003, 41, 267–272. [Google Scholar] [CrossRef] [PubMed]
- Posteraro, B.; Sanguinetti, M.; Sanglard, D.; La Sorda, M.; Boccia, S.; Romano, L.; Morace, G.; Fadda, G. Identification and characterization of a cryptococcus neoformans atp binding cassette (abc) transporter-encoding gene, cnafr1, involved in the resistance to fluconazole. Mol. Microbiol. 2003, 47, 357–371. [Google Scholar] [CrossRef] [PubMed]
- Perfect, J.R.; Dismukes, W.E.; Dromer, F.; Goldman, D.L.; Graybill, J.R.; Hamill, R.J.; Harrison, T.S.; Larsen, R.A.; Lortholary, O.; Nguyen, M.H.; et al. Clinical practice guidelines for the management of cryptococcal disease: 2010 update by the infectious diseases society of america. Clin. Infect. Dis. 2010, 50, 291–322. [Google Scholar] [CrossRef] [PubMed]
- Brown, G.D.; Denning, D.W.; Gow, N.A.; Levitz, S.M.; Netea, M.G.; White, T.C. Hidden killers: Human fungal infections. Sci. Transl. Med. 2012, 4, 165rv113. [Google Scholar] [CrossRef] [PubMed]
- Mohammadzadeh, R. Novel agents for antimicrobial solutions. Eye Contact Lens Sci. Clin. Pract. 2016, 42, 401–402. [Google Scholar] [CrossRef] [PubMed]
- Raman, N.; Pothiraj, K.; Baskaran, T. DNA-binding, oxidative DNA cleavage, and coordination mode of later 3d transition metal complexes of a schiff base derived from isatin as antimicrobial agents. J. Coord. Chem. 2011, 64, 3900–3917. [Google Scholar] [CrossRef]
- Xiang, Y.; Fu, C.; Breiding, T.; Sasmal, P.K.; Liu, H.; Shen, Q.; Harms, K.; Zhang, L.; Meggers, E. Hydrolytically stable octahedral silicon complexes as bioactive scaffolds: Application to the design of DNA intercalators. Chem. Commun. 2012, 48, 7131–7133. [Google Scholar] [CrossRef] [PubMed]
- Henker, J.; Glockner, S.; Meggers, E. Dinuclear ruthenium-silicon complexes as DNA and g4 DNA binding agents. J. Biol. Inorg. Chem. 2014, 19, S367. [Google Scholar]
- Fu, C.; Harms, K.; Zhang, L.L.; Meggers, E. DNA mismatch recognition by a hexacoordinate silicon sandwich-ruthenium hybrid complex. Organometallics 2014, 33, 3219–3222. [Google Scholar] [CrossRef]
- Kummer, D.; Gaisser, K.E.; Seshadri, T. Contributions to chemistry of halosilane adducts.10. Bis(2,2′-bipyridine) complexes of silicon, direct synthesis, structure, and properties. Chem. Ber. Recl. 1977, 110, 1950–1962. [Google Scholar] [CrossRef]
- Peloquin, D.M.; Schmedake, T.A. Recent advances in hexacoordinate silicon with pyridine-containing ligands: Chemistry and emerging applications. Coord. Chem. Rev. 2016, 323, 107–119. [Google Scholar] [CrossRef]
- Erkkila, K.E.; Odom, D.T.; Barton, J.K. Recognition and reaction of metallointercalators with DNA. Chem. Rev. 1999, 99, 2777–2795. [Google Scholar] [CrossRef] [PubMed]
- Hannon, M.J. Supramolecular DNA recognition. Chem. Soc. Rev. 2007, 36, 280–295. [Google Scholar] [CrossRef] [PubMed]
- Keene, F.R.; Smith, J.A.; Collins, J.G. Metal complexes as structure-selective binding agents for nucleic acids. Coord. Chem. Rev. 2009, 253, 2021–2035. [Google Scholar] [CrossRef]
- Liu, H.K.; Sadler, P.J. Metal complexes as DNA intercalators. Acc. Chem. Res. 2011, 44, 349–359. [Google Scholar] [CrossRef] [PubMed]
- Medici, S.; Peana, M.; Nurchi, V.M.; Lachowicz, J.I.; Crisponi, G.; Zoroddu, M.A. Noble metals in medicine: Latest advances. Coord. Chem. Rev. 2015, 284, 329–350. [Google Scholar] [CrossRef]
- Lu, L.; Liu, L.J.; Chao, W.C.; Zhong, H.J.; Wang, M.; Chen, X.P.; Lu, J.J.; Li, R.N.; Ma, D.L.; Leung, C.H. Identification of an iridium(iii) complex with anti-bacterial and anti-cancer activity. Sci. Rep. 2015, 5, 14544. [Google Scholar] [CrossRef] [PubMed]
- Zhai, B.; Wu, C.; Wang, L.; Sachs, M.S.; Lin, X. The antidepressant sertraline provides a promising therapeutic option for neurotropic cryptococcal infections. Antimicrob. Agents Chemother. 2012, 56, 3758–3766. [Google Scholar] [CrossRef] [PubMed]
- Gorle, A.K.; Feterl, M.; Warner, J.M.; Wallace, L.; Keene, F.R.; Collins, J.G. Tri- and tetra-nuclear polypyridyl ruthenium(ii) complexes as antimicrobial agents. Dalton Trans. 2014, 43, 16713–16725. [Google Scholar] [CrossRef] [PubMed]
- Li, F.F.; Collins, J.G.; Keene, F.R. Ruthenium complexes as antimicrobial agents. Chem. Soc. Rev. 2015, 44, 2529–2542. [Google Scholar] [CrossRef] [PubMed]
- Zipperer, A.; Konnerth, M.C.; Laux, C.; Berscheid, A.; Janek, D.; Weidenmaier, C.; Burian, M.; Schilling, N.A.; Slavetinsky, C.; Marschal, M.; et al. Human commensals producing a novel antibiotic impair pathogen colonization. Nature 2016, 539, 314. [Google Scholar] [CrossRef] [PubMed]
- Calderazzo, F.; Forte, C.; Marchetti, F.; Pampaloni, G.; Pieretti, L. Reaction of phenanthrene-9,10-dione with phenanthrene-9,10-diol: Synthesis and characterization of the first ortho-quinhydrone derivative. Helv. Chim. Acta 2004, 87, 781–789. [Google Scholar] [CrossRef]
- Ye, R.R.; Ke, Z.F.; Tan, C.P.; He, L.; Ji, L.N.; Mao, Z.W. Histone-deacetylase-targeted fluorescent ruthenium(ii) polypyridyl complexes as potent anticancer agents. Chem. A Eur. J. 2013, 19, 10160–10169. [Google Scholar] [CrossRef] [PubMed]
- Venkataramana, G.; Dongare, P.; Dawe, L.N.; Thompson, D.W.; Zhao, Y.M.; Bodwell, G.J. 1,8-Pyrenylene-ethynylene macrocycles. Org. Lett. 2011, 13, 2240–2243. [Google Scholar] [CrossRef] [PubMed]
Sample Availability: Samples of the complexes 1–3 are available from the authors. |
© 2017 by the authors. Licensee MDPI, Basel, Switzerland. This article is an open access article distributed under the terms and conditions of the Creative Commons Attribution (CC BY) license (http://creativecommons.org/licenses/by/4.0/).